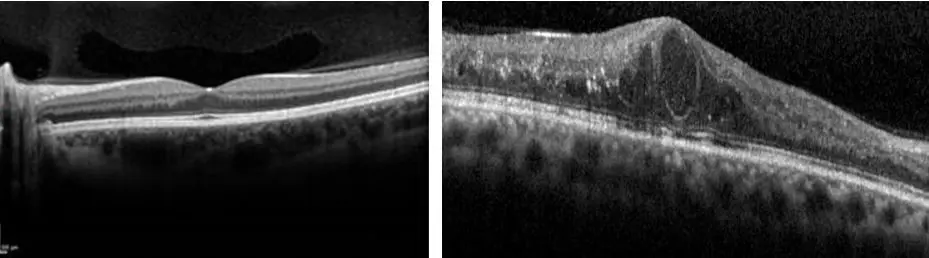
Desprendimiento de Retina

Blefaritis es una inflamación del borde externo de los párpados donde nacen las pestañas.
En esa área existen pequeños poros en el borde interno de los párpados por donde drenan glándulas que producen secreción oleosa y acuosa. Cuando esas glándulas se tapan debido a infecciones o exceso de secresión grasa por las glándulas de Meibomio ocurre Meibomitis. Ambas traen como consecuencia alteración de la lubricación ocular.
Hay que hacer un tratamiento y adoptar cuidados especiales para recuperar la función normal.
El glaucoma es una enfermedad que causa daño al nervio óptico del ojo este es la vía que transmite la imagen desde los ojos hacia el cerebro y a medida que se daña, se altera el campo visual y áreas ciegas se van desarrollando.
En un ojo sano, continuamente se produce una pequeña cantidad de un líquido claro llamado humor acuoso, con funciones muy importantes como nutrición. Este debe drenarse de manera equilibrada para mantener la presión ocular normal. Si el líquido no drena correctamente, puede aumentar la presión ocular y producir daño del nervio óptico de manera progresiva. Muchas personas no perciben el Glaucoma en sus estadíos iniciales porque no hay síntomas y el paciente no advierte que tiene la presión ocular elevada y consulta cuando la disminución visual aparece y puede ser un diagnóstico tardío o la enfermedad esté avanzada.
El glaucoma sin tratamiento puede llevar a la ceguera total. La enfermedad no suele dar síntomas en su comienzo y su tratamiento correcto y precoz puede ayudar a preservar la visión. Lo importante es el reconocimiento precoz de la enfermedad para poder tratarla de manera exitosa .Por eso es importante realizar un examen de rutina con el médico oftalmólogo.
EXÁMENES PREVENTIVOS Y DIAGNÓSTICOS
Exámenes oftalmológicos realizados anualmente después de 35 años especialmente si tiene antecedentes familiares .Toma de presión ocular, campo visual computarizado estudios del nervio óptico (OCT.HRT).
Conozca el tratamiento quirúrgico leyendo: CIRUGÍA DE GLAUCOMA
Es cuando la retina se separa de la parte posterior del ojo. La retina no funciona cuando está desprendida y esto hace que la visión sea borrosa. El desprendimiento de retina es un problema grave. Un oftalmólogo debe evaluarlo de inmediato o usted puede perder la visión en ese ojo.
¿Cómo se produce un desprendimiento de retina?
A medida que envejecemos, el gel vítreo del interior del ojo presenta cambios que en algunas personas con determinados factores predisponentes (por ejemplo: adhesión de dicho gel a la retina muy fuerte, o miopía elevada, entre otros), produce un evento desafortunado como un desprendimiento de retina, que en muchas ocasiones se produce de manera espontánea sin haber recibido un golpe.
¿Cómo se diagnostica el desprendimiento de retina?
En la mayoría de los casos es clínico (con un examen que requiere dilatación de los ojos y observación por su oftalmólogo). En algunos casos puede ser necesaria una ecografía ocular para llegar al diagnóstico. Se puede estudiar, además la presencia de compromiso de visión central mediante tomografía de coherencia óptica (oct).
¿Cómo se trata el desprendimiento de retina?
Conozca su resolución quirúrgica leyendo: CIRUGÍA DE RETINA CON VITRÉCTOMO STELLARIS

Fig- síntomas: moscas volantes, destellos, pérdida de campo de visión.
Son pequeños puntos, círculos o manchas oscuras móviles que muchas personas ven en su campo visual. En realidad esas manchas son opacificación o pérdida de transparencia de células del vítreo que es el gel que rellena el ojo y lo que se ve es la sombra que proyecta. A veces están presentes en el centro de la visión otras al costado, se mueven y a veces desaparecen fuera del eje visual se ponen de manifiesto especialmente cuando se mira una pared blanca o algo liso. Son incómodas pero no graves.
Aunque no sean graves, las moscas volantes deben despertar cuidado si comienzan de modo súbito o con cierta frecuencia. A medida que el vítreo disminuye su volumen puede traccionar la retina provocando un desgarro y posterior D.R.. Por eso es muy importante la consulta con el médico oftalmólogo para con exámenes específicos visualizar y descartar cambios en la retina con otro tipo de consecuencias más serias.
Pautas de alarma: si ve flash o relámpagos consulte de inmediato al oftalmólogo.
La DMAE (degeneración macular asociada a la edad) es una enfermedad degenerativa de la mácula (zona que utilizamos para la visión central) Representa la primera causa de baja visión irreversible en mayores de 65 años. Siendo la edad el principal factor de riesgo; actualmente se demostró una gran asociación genética (de importancia conocer si sus familiares la padecieron). Además de la carga genética, los factores como el tabaquismo, hipertensión, obesidad y otros, constituyen factores ambientales que predisponen a la DMAE.
Se daña progresivamente los fotorreceptores y el epitelio pigmentario de la mácula responsables de la visión de los colores y de agudeza visual. La DMAE le hace perder la visión central. No puede ver los detalles finos, ni de cerca ni de lejos.

Visión con Maculopatía.
Comúnmente se la clasifica en dos tipos que pueden alternarse según la evolución de la enfermedad:
• Degeneración macular seca o NO EXUDATIVA: Es la forma más frecuente de presentación (más del 80% de los casos) y evoluciona de forma lenta. No existen tratamientos actuales que puedan revertir su evolución.
• Degeneración macular EXUDATIVA (húmeda): Es menos frecuente, pero de evolución rápida y de pronóstico reservado. Se caracteriza por la formación de neovasos debajo de la retina. Este crecimiento produce una incapacidad de los vasos para contener líquido y por ello se la llama húmeda (produciendo edema macular).
¿Cómo se previene la degeneración macular asociada a la edad?
Si bien la genética y la edad no se pueden modificar, se puede trabajar sobre los factores ambientales que promueven su desarrollo: dieta equilibrada, menor exposición solar, evitar el tabaquismo.
¿Cómo se detecta la degeneración macular asociada a la edad?
Con la tecnología que disponemos actualmente , se puede detectar antes de que los síntomas visuales comiencen. Por ello un examen de rutina de valoración visual, fondo de ojos y estudios complementarios pertinentes (Tomografía de coherencia óptica, OCT0 en un gran número de casos, son suficientes para realizar el diagnóstico.
¿Cómo se trata la degeneración macular asociada a la edad?
Al ser una enfermedad tan frecuente, la ciencia actual en el desarrollo de fármacos, logró elaborar mediaciones que solo sirven en la etapa neovascular (maculopatía húmeda). Dicha medicación se coloca en el interior del ojo (inyecciones intravitreas) con un plan de aplicaciones que varía y se personaliza según cada paciente.
Con estos fármacos llamados antiangiogénicos, se intenta frenar la enfermedad y así poder contener e incluso disminuir los síntomas ocasionados por la enfermedad.
Para la etapa SECA de la enfermedad, existen medicamentos antioxidantes con suplemento vitamínico que en pacientes muy específicos se demostró su utilidad, por ello no siempre se le va a indicar utilizarlos.
IMPORTANTE: EN LA FORMA MAS AVANZADA DE LA ENFERMEDAD, SE PRODUCE PERDIDA DE VISION CENTRAL. ESTO DIFICULTA LA CAPACIDAD VER EL CENTRO DE LAS COSAS, PERO NO GENERA PERDIDA COMPLETA DEL CAMPO VISUAL (CONSERVARÁ VISION PERIFERICA).

Izquierda: Retina Normal | Centro: DMAE Atrófica | Derecha: DMAE Húmeda
AGUJERO MACULAR
Se define como agujero macular a la pérdida de espesor completo del centro de la retina, zona que llamamos mácula, y se presenta de forma idiopática (influenciada por la edad, desprendimiento del vítreo que se contrae y tracciona el centro de la retina), y otras formas como traumática (un golpe fuerte), por miopia,entre otras.
Similar a la degeneración macular asociada a la edad, los síntomas que producen son en el centro de la visión (deformación al visualizar líneas, dificultad para enfocar el centro de las cosas).
El tratamiento actual es quirúrgico, mediante un procedimiento llamado vitrectomía. En esta cirugía se realiza un peeling de la capa más superficial de la retina y se coloca una burbuja de gas, la cual empujará la zona reparada y mejorará la probabilidad de que el agujero cierre.
Una vez que se desarrolla esta enfermedad, la posibilidad de curación espontánea sin tratamiento es muy poco frecuente, por este motivo, una vez diagnosticado, se le indicará cirugía para corregir la pérdida de tejido.
IMPORTANTE: AL IGUAL QUE EN MUCHAS ENFERMEDADES QUE OCURREN EN UN SOLO OJO, MUCHAS VECES LOS SÍNTOMAS PASAN DESAPERCIBIDOS A NO SER QUE UNO SE TAPE UN OJO Y VERIFIQUE LA DIFERENCIA ENTRE AMBOS OJOS, PORQUE CON LOS DOS OJOS ABIERTOS MUCHAS VECES NO NOTAMOS LA DIFERENCIA

Izquierda: Mácula Normal | Derecha: Agujero Macular
Conozca el tratamiento quirúrgico leyendo: CIRUGÍA DE RETINA CON VITRÉCTOMO STELLARIS
El Queratocono es una enfermedad progresiva en la cual la córnea adopta una forma cónica irregular. La causa es desconocida.
Normalmente comienza en la adolescencia y después progresa lentamente, aunque puede volverse estacionario en cualquier momento. A veces también aparece en edades más tardías y en este caso la enfermedad no degenera tanto, la agudeza visual suele ser algo mejor y los astigmatismos más bajos que en el caso de edades tempranas.
Visión borrosa y distorsión de las imágenes, son los primeros síntomas del queratocono. En los primeros estadíos, la visión puede estar sólo ligeramente afectada, causando fotofobia, aumento de sensibilidad a la luz e irritación. Enfermedad es bilateral, aunque el grado evolutivo puede ser diferente, asimétrica. La córnea se va adelgazando y deformando con el desarrollo del queratocono ocasionando un astigmatismo cada vez más elevado que raramente puede ser tratado mediante anteojos. La topografía corneal permite el diagnóstico precoz y diferencia el queratocono con otras enfermedades, y nos da la información necesaria para el tratamiento del mismo, el adelgazamiento de la cornea se mide paquimetría.
Se sospecha un Queratocono cuando una persona joven con astigmatismo y miopía no logra una buena visión con sus anteojos y cambia de graduación frecuentemente. A medida que la enfermedad avanza, las lentes de contacto son una opción para mejorar la visión. Pero para aquellos pacientes que no las toleran, existen varias opciones quirúrgicas, dependiendo del grado de evolución del queratocono se indican:
1) Cross-linking.
2) Anillos intraestromales.
3) Transplante de córnea.
Conozca el tratamiento quirúrgico leyendo: TRATAMIENTO DE QUERATOCONO Y OTRAS ECTASIAS
El cristalino es una lente clara y transparente situada en la parte anterior del ojo que enfoca los rayos de luz en la retina, en el fondo del ojo. Esa lente cuando es transparente se llama cristalino y cuando se pone opaca es catarata. Se confunde a veces con otras patologías externas provoca disminución paulatina de la agudeza visual, el paciente refiere como que ve a traves de un vidrio sucio.
Hay varios tipos de catarata:
•SENIL
•CONGENITA
•TRAUMATICA
•SECUNDARIA
Otras causas como medicamentos, enfermedades como diabetes, miopía predisponen al desarrollo precoz de Catarata.
Conozca el tratamiento quirúrgico leyendo: CIRUGÍA DE CATARATA
El ojo seco es una patología frecuente, más de 300 millones de personas en el mundo la sufren.
Padecer el síndrome del Ojo Seco puede disminuir nuestra calidad de vida y dificultar las actividades diarias como leer, practicar deporte o conducir.
Además, ninguna edad está exenta de padecer esta patología puesto que con el uso de la tecnología se presenta el síndrome de síndrome de Ojo Seco entre los usuarios digitales a cualquier edad.
Los síntomas varían de una persona a otra y según la gravedad del Ojo Seco:
• Ardor
• Irritación
• Enrojecimiento
• Fatiga ocular
• Visión fluctuante o borrosa
• Sensación de arenilla
Puede ocurrir que los ojos segreguen más lágrimas de lo habitual y estemos igualmente hablando de Ojo Seco. Esta reacción suele ocurrir cuando el ojo no tiene suficiente lubricación y el propio ojo envía un estímulo para pedir más lubricación inundándose con lágrimas de emergencia. Sin embargo, estas lágrimas están compuestas mayoritariamente por agua y no tienen buena calidad de lubricación o la composición de la lágrima es anormal. Es entonces cuando se debe valorar un tratamiento de ojo seco según sea el origen.
LAS CAUSAS
Pueden estar relacionadas tanto con la glándula lagrimal principal – responsable de la parte acuosa de la lágrima – como de las glándulas de Meibomio, responsables de la parte lipídica de la película lagrimal.
Para diagnosticar de manera eficaz la causa real de esta patología ocular, se pueden realizar pruebas diagnósticas tales como:
• Test de Schirmer: se aplica una tira de papel de filtro debajo del párpado inferior para medir la cantidad de lágrima producida bajo diferentes condiciones.
• Evaluación de la superficie de la córnea con colirios colorantes especiales.
• Biomicroscopia:
• Test de Osmoralidad: se realiza el análisis de una lágrima para averiguar su calidad a partir de su composición.
• NBUT: tiempo de ruptura lagrimal. Se trata de medir en segundos el momento en el cual se rompe la película lagrimal.
• Meibomiografía: tecnología que permite, mediante diferentes aparatos diagnósticos no invasivos, evaluar la morfología de las glándulas de Meibomio. De esta forma es posible saber si están en buenas condiciones o si existe una atrofia.
Y es que para llegar a un diagnóstico correcto y encontrar la causa que provoca este síndrome hay que realizar un examen exhaustivo:
• Revisión de los párpados,
• Controlar la frecuencia del parpadeo,
• Determinar la cantidad y calidad de producción lagrimal,
• Medir la sensibilidad corneal.
Cuando se parpadea, se esparce una capa de lágrimas que mantiene su superficie suave, limpia y lisa. La película lagrimal es muy importante para tener una buena visión y está compuesta por tres capas:
• Capa lipídica: es la parte exterior de la película lagrimal y se genera en las glándulas de Meibomio;
• Capa acuosa: situada en el medio de las tres capas es la que limpia el ojo, lavando las partículas que no le pertenecen y proviene de los párpados;
• Capa de mucosa: producida en la conjuntiva, ayuda a esparcir la capa acuosa sobre la superficie del ojo, para mantenerlo húmedo. Sin la presencia de mucosa, las lágrimas no se adhieren al ojo.

Cualquier problema con uno de estos componentes de la película lagrimal puede tener como consecuencia una inestabilidad lagrimal derivando en una sensación de Ojo Seco.
Si las glándulas de Meibomio no producen o no segregan suficiente óleo, es posible que la película lagrimal se evapore demasiado rápido y considera como Ojo Seco evaporativo.
La deficiencia acuosa del ojo seco se da cuando las glándulas lagrimales fallan en la producción de fluido acuoso siendo insuficiente como para mantener los ojos adecuadamente humectados.
Inflamación de las conjuntivas, membrana que tapiza el ojo. Pueden tener numerosas causas bacterianas, virales, alérgicas, químicas, etc., con características similares pero con rasgos que hacen al diagnóstico diferencial por eso es importante la consulta al profesional oftalmólogo y no auto medicarse.
Las vías lagrimales son el sistema de drenaje de la lágrima desde el ojo hacia la nariz. Está formada por una sucesión de “tuberías” que comienzan en los puntos lagrimales (puerta de entrada de la vía lagrimal) uno superior y otro inferior y continúan con los canalículos, el saco lagrimal y el conducto lacrimonasal (que desemboca en la nariz).
Las vías lagrimales pueden obstruirse de forma parcial o total en cualquiera de las partes de su trayecto. Cuando esto sucede, la lágrima no puede drenar hacia la nariz, se acumula en el ojo y cae hacia la mejilla generando lagrimeo. El lagrimeo es muy incómodo y molesto para el paciente.
Un oftalmólogo especializado en vías lagrimales diagnosticará a través del examen oftalmológico y de pruebas específicas, cual es el sitio de la obstrucción y si ésta es completa o parcial, ya que el tratamiento será diferente según el caso.
Cuando la obstrucción se produce en la última parte de la vía (conducto lacrimonasal) la lágrima se acumula en el saco lagrimal y puede infectarse e inflamar el saco lagrimal generando una DACRIOCISTITIS (inflamación del saco lagrimal). La Dacriocistitis se caracteriza por enrojecimiento, tumoración y dolor en el ángulo interno del ojo, que puede drenar pus por el punto lagrimal o hacia el exterior por la piel. En este caso se requiere tratamiento con antibióticos y la posterior corrección quirúrgica de la obstrucción que la generó.
Conozca el tratamiento quirúrgico leyendo: CIRUGÍA DE VÍAS LAGRIMALES
PTOSIS
Se la define como la imposibilidad de elevar el párpado superior adecuadamente. Existen formas leves, en donde el párpado no tapa la pupila, y formas severas en donde el ojo está completamente tapado. Existen diversas causas, entre ellas la blefarochalasis (exceso de piel palpebral), un estiramiento del tendón que une el párpado con el músculo que lo eleva, enfermedades musculares o neurológicas, etc.
La ptosis adquirida se puede corregir mediante una cirugía palpebral para ajustar el tendón o, una blefaroplastia, en caso que sea por motivo estético. Existen varias técnicas para realizarla y en la mayoría de los casos no quedan cicatrices. Es una cirugía ambulatoria, con anestesia local y con un posoperatorio corto.
ENTROPIÓN
El entropión es una mala posición del párpado el cual se encuentra dirigido hacia el ojo. Esto hace que las pestañas rocen la córnea produciendo sensación de cuerpo extraño y posible riesgo de generase úlceras e infecciones con intenso dolor.
La forma más común de entropión es la Involucional, generada por la laxitud de los tendones del párpado. Suele ser muy molesto para el paciente, y el tratamiento es quirúrgico. Se realiza bajo anestesia local, y el porcentaje de éxito de la misma es mayor al 95%, restituyendo la función normal del parpado.
ECTROPIÓN
El ectropión es, al igual que el entropión, una patología del borde palpebral. La causa más frecuente es la Involutiva (debido a la edad), donde ocurre una hiperelasticidad de los tejidos perioculares. Entre otras causas, también está la parálisis facial. En el ectropión, el párpado se evierte hacia fuera dejando de estar en contacto con el globo ocular y el ojo no logra un buen cierre. A largo plazo, puede traer consecuencias graves por exposición, ya sea irritación, queratitis y úlceras crónicas.
En este caso lo que se realiza es una cirugía para restablecer la posición palpebral normal, realizando la técnica de tira tarsal lateral, estirando y anclando el parpado en su ángulo lateral. Se realiza con anestesia local y dura aproximadamente 30 min.
Conozca el tratamiento quirúrgico leyendo: CIRUGIA OCULOPLÁSTICA, RECONSTRUCTIVA Y ESTÉTICA
MIOPÍA
Se forma por delante de la retina y por ello se presenta dificultad para la visión lejana.
Llamamos miopía patológica o “magna” aquella miopía elevada (mayor a 6 dioptrías) en la que se encuentran enfermedades relacionadas a la misma, por ejemplo:
• Desprendimiento de retina: la miopía es un factor de riesgo que aumenta con la cantidad de dioptrías.
• Maculopatía relacionada a la miopía: neovascularización retiniana, atrofia macular, agujero macular.
• Desprendimiento vítreo: que puede llevar al desprendimiento de retina o puede pasar desapercibido.
• Glaucoma: es más frecuente padecerlo y además los ojos miopes son más sensibles a los cambios de presión.
Síntomas relacionados a miopía patológica:
a. Moscas volantes (en mayor cantidad o diferentes a las habituales, o nuevas si no las veía)
b. Manchas/sombras/cortinas en su campo de visión.
c. Deformación de líneas o de objetos.
d. Dificultad para enfocar el centro durante la lectura.
e. Flashes, luces, relámpagos.
IMPORTANTE: Haberse operado de miopía (excimer laser/lente intraocular, entre otros) no implica que el ojo operado sea un ojo normal. El riesgo de padecer patologías oculares por la miopía sigue existiendo. Por ese motivo es muy importante seguir realizando los controles anuales habituales y fondo de ojos para valorar y diagnosticar cualquier alteración que pueda pasar inadvertida por la falta de síntomas.
HIPERMETROPÍA
Defecto del ojo que consiste en la imposibilidad de ver con claridad los objetos próximos debido a un defecto de convergencia del cristalino, del largo axil, son ojos cortos, que hace que los rayos luminosos queden enfocados detrás de la retina.
Se corrige con lentes biconvexas, lentes de contacto o cirugia refractiva con excimer láser, también con lentes fáquicas intraoculares cuando el defecto supera el rango de corrección con láser.
ASTIGMATISMO
En el astigmatismo hay variaciones de la curvatura de la córnea en sus diferentes meridianos hacen que los rayos de luz no se enfoquen en un solo punto, por eso la imagen esta desenfocada el paciente ve con poca nitidez como con falta de foco en la imagen. Se corrige con lentes aéreas tóricas, lentes de contacto, tratamiento con excimer láser y lentes fáquicas ICL
PRESBICIA
La presbicia es un proceso evolutivo por el cual el ser humano va perdiendo su capacidad para ver de cerca por deterioro de la acomodación.
En el proceso de acomodación, de producen varios cambios dentro del ojo para que este fenómeno ocurra.
El ojo debe modificar su cristalino, músculo ciliar, pupila, etc. para hacer foco cercano y es lo que va perdiendo a partir de los 40 años.
El paciente comienza a necesitar corrección con lentes para la visión cercana, puede acceder al tratamiento médico de la presbicia con Método Benozzi (gotas) o en casos con indicación precisa y muy bien estudiados correción con lentes intraoculares multifocales.
Para conocer más, vea: EXCIMER LÁSER PARA MIOPÍA, HIPERMETROPÍA Y ASTIGMATISMO
La uveítis Lejos de ser una enfermedad, es un síndrome, un conjunto específico de síntomas y signos causados por las más variadas etologías.
El término uveítis no se refiere solamente a un proceso inflamatorio limitado al tracto uveal, sino a todo proceso inflamatorio intraocular mediado por el sistema inmunológico. Dependiendo de la localización anatómica se puede dividir en anterior, intermedia y posterior, según la extensión del proceso inflamatorio.
Las uveítis se determinan también según las estructuras intraoculares involucradas como las iritis, iridociclitis, retinitis, coroiditis, vasculitis, papilitis.
Puede estar causada por trastornos autoinmunes como la artritis reumatoidea o la espondilitis anquilosante, causas infecciosas como la toxoplasmosis, tbc, sífilis y en muchos casos,por virus como el herpes y en muchos casos, la causa se desconoce.
Siempre disminuye la visión en mayor o menor grado ,se acompaña de congestión a veces de dolor. Es importante la consulta al oftalmólogo para el diagnóstico precoz y el tratamiento adecuado Es necesario el enfoque multidisciplinario en estas entidades ya que el abanico de posibles causas es variada y en muchas ocasiones se necesita de tratamiento sistémico mas que tópicos.
Trastorno en el que los ojos pierden el paralelismo y no miran exactamente en la misma dirección al mismo tiempo.
Las causas de estrabismo pueden ser varias, el mal funcionamiento de los músculos de origen congénito o hereditario, secundario a defectos refractivos (hipermetropías, miopías) por lesión en un nervio, traumáticas, etc.
El síntoma principal es que los ojos están desviados, pierden el paralelismo, no están alineados y no miran exactamente en la misma dirección, al mismo tiempo.
Generalmente, la desviación de los ojos se puede corregir con un tratamiento temprano. Existen varias opciones de tratamiento, como el uso de anteojos especiales o parches para el desarrollo de la agudeza visual que es lo más importante y la cirugía para corregir la desviación en los casos necesarios .Es muy importante el examen precoz del niño con el oftalmólogo para detectar estos problemas que a veces no son tan notables y evitar la ambliopía, esto es que la visión de un ojo no se desarrolle (”ojo vago”).
Conozca el tratamiento quirúrgico leyendo: ESTRABISMO (Cirugía correctora de músculos extraoculares)
El pterigión es un sobre-crecimiento de la conjuntiva que avanza sobre la córnea.
No tiene una causa única sino multifactorial. La exposición prolongada al sol (rayos UV) y las condiciones climáticas adversas (viento, sequedad ambiental, etc) favorecen su formación. Puede presentar distintos tamaños y por esto avanzar hacia el centro de la córnea, lo que nos permite clasificarlos en distintos grados. Los pacientes lo advierten al mirarse al espejo. Puede inflamarse y generar molestias como dolor, picazón, sensación de arenilla. En estos casos requiere tratamiento con gotas antinflamatorias y lubricantes. Otras veces no se logra respuesta a las gotas y debe operarse. También puede manifestarse por un astigmatismo secundario por aplanar la córnea con su crecimiento y que el paciente note una disminución de su visión.
El oftalmólogo determinará si es conveniente realizar tratamiento médico o la resección quirúrgica con autoinjerto de conjuntiva. La cirugía es ambulatoria y se realiza con anestesia local.
Conozca el tratamiento quirúrgico leyendo: CONJUNTIVOPLASTÍA PARA PTERIGIÓN
ORZUELOS
Son infecciones de las glándulas sebáceas de los parpados producidas por las bacterias que forman parte de la flora normal de nuestra piel. No son contagiosos
Pueden ser externos, si afectan las glándulas de Zeiis anexas al folículo piloso de la pestaña; o internos cuando afectan a las glándulas de Meibomio del espesor del parpado.
En ambos casos generaran dolor, tumoración y enrojecimiento que aparece de forma aguda. Son molestos y pueden drenar secreción espontáneamente.
Su oftalmólogo le indicara que ungüento antibiótico colocarse para el tratamiento y que otras medidas ayudaran a mejorar las molestias. Ocasionalmente pueden requerir drenaje quirúrgico.

CHALAZION
es una lesión quística que se produce por la inflamación granulomatosa crónica y aséptica (no infecciosa) de las glándulas de Meibomio. Se caracteriza por una aparición más lenta, de una tumoración que puede ser colorada o no. Genera menos molestias que los orzuelos frecuentemente. A veces no duele y el paciente consulta porque se ve o se palpa la tumoración. También pueden aplicarse ungüentos antibióticos pero la mayoría de las veces requiere drenaje quirúrgico para su resolución completa.

La enfermedad ocular diabética es un término que se utiliza para varios problemas oculares relacionados a la diabetes. Dentro del gran espectro de esta entidad, existe un factor en común: la evolución tórpida de su diabetes (tiempo prolongado de la enfermedad, valores elevados de glucemia, hemoglobina glicosilada alta, falta de cumplimiento en la dieta, entre otros).
La enfermedad ocular diabética incluye:
• RETINOPATIA DIABÉTICA:
Es una afección que se produce cuando los vasos sanguíneos de la retina se inflaman, presentan escapes o se cierran por completo. También se pueden desarrollar nuevos vasos sanguíneos anormales.
Quienes tienen diabetes o mal control de glucosa en la sangre están en riesgo de retinopatía diabética. Aumenta también el riesgo entre mayor sea el tiempo que alguien haya tenido diabetes.
La retinopatía diabética tiene un curso progresivo y se la clasifica en retinopatía NO PROLIFERATIVA, aquella en la que lentamente se producen cambios en los vasos del ojo desde LEVES hasta SEVEROS, y retinopatía PROLIFERATIVA, de mayor gravedad y requiere resolución ya sea laser o quirúrgica.
La retinopatía diabética se estudia mediante RETINOGRAFIA (con o sin contraste) y tiene un perfil amplio de tratamientos según la magnitud de la lesión, desde controles periódicos hasta laser o cirugía vitreoretinal.
Es fundamental el control estricto de su GLUCEMIA (glucosa en sangre) y familiarizarse con los valores de HEMOGLOBINA GLICOSILADA (puede encontrarlo en el examen de sangre solicitado por su diabetólogo con las siglas HB1AC).

Figura Izquiera: Retinopatía No Proliferativa | Figura Derecha: Retinopatía Proliferativa
• EDEMA MACULAR DIABÉTICO
Ocurre cuando se acumula líquido en la retina y produce inflamación y disminución de la visión. El edema macular diabético puede llevar a pérdida permanente de la visión. Se lo estudia mediante ANGIO-OCT (estudio de alta complejidad) y por lo general se trata con inyecciones intraoculares para reducir la cantidad de líquido.
Figura Izquierda: Macurla Normal | Figura Derecha: Edema Macular Diabético
• DIABETES Y CATARATAS
La catarata es una opacidad del cristalino o lente del ojo (normalmente, éste es transparente), la cual causa problemas de la visión.
El exceso de glucosa en la sangre producido por diabetes puede causar catarata de forma precoz (antes de la edad promedio habitual). Es posible que requiera cirugía para retirar el cristalino que se ha opacificado. Mantener un buen control de su nivel de glucosa en sangre ayuda a evitar la opacidad precoz del cristalino.
• DIABETES Y GLAUCOMA
El glaucoma comprende un grupo de enfermedades que causan daño al nervio óptico de sus ojos. Este daño lleva a una pérdida de visión irreversible. Ser diabético duplica la probabilidad de tener glaucoma. Se lo estudia mediante la toma de presión ocular, el fondo de ojos y estudios complementarios como la tomografía de nervio óptico y el campo visual computarizado. Por lo general requiere tratamiento con gotas que disminuyen la presión ocular y en algunos casos requiere cirugía láser o invasiva.
















